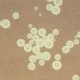

A Fundação Oswaldo Cruz (Fiocruz) deverá receber, neste sábado (12), mais um lote de ingrediente farmacêutico ativo (IFA), suficiente para a produção de cerca de seis...


O Ministério da Saúde informou na noite de hoje (11) que um lote de 2,7 milhões de doses da vacina AstraZeneca foi recebido. Pela manhã, a...


O estado do Rio de Janeiro registrou queda no número de óbitos por covid-19 na 20ª semana epidemiológica do ano, compreendida entre os dias 16 e...


Os novos casos de covid-19 tiveram alta de 3%, o que o Ministério da Saúde considera estabilidade. É o que mostra o novo boletim epidemiológico do...


O total de pessoas que contraíram a covid-19 desde o início da pandemia no Brasil subiu para 17.296.118. Nas últimas 24 horas, houve 85.149 novos ocorrências...

O Sistema Único de Saúde (SUS) passará a fazer exames que podem identificar fungos Cryptococcus que agem de forma prejudicial sobre o sistema nervoso. Os procedimentos...


O presidente Jair Bolsonaro voltou a defender o uso da hidroxicloroquina para o tratamento da covid-19. Na tarde desta sexta-feira (11), durante cerimônia para a entrega...


O presidente Jair Bolsonaro voltou a defender o uso da hidroxicloroquina para o tratamento da covid-19. Na tarde desta sexta-feira (11), durante cerimônia para a entrega...


A microbiologista e diretora-presidente do Instituto Questão de Ciência, Natália Pasternak, afirmou nesta sexta-feira (11) à Comissão Parlamentar de Inquérito (CPI) da Pandemia do Senado que...


Dois projetos de desenvolvimento tecnológico e inovação do Centro Henrique Penna (CHP), parte do Complexo Tecnológico de Vacinas (CTV) da Fundação Oswaldo Cruz (Fiocruz), receberam R$...